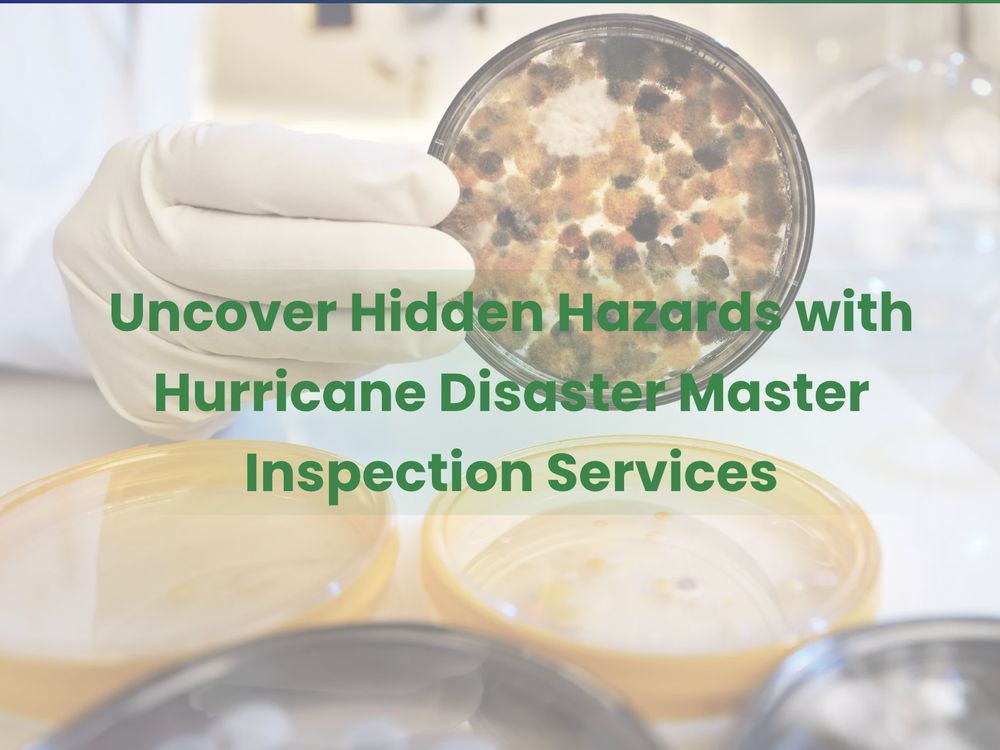
Hurricane Disaster Master's Mold & Air Quality - mold inspector in Estero, FL

Hurricane Disaster Master's Mold & Air Quality
Mold Inspector in Estero, Florida
Client Reviews
5
out of 5
About Hurricane Disaster Master's Mold & Air Quality
Need to Document Your Mold Compliance?
MoldReport helps landlords and property managers maintain court-ready mold compliance documentation. Document everything. Defend against mold lawsuits.
Start Documenting